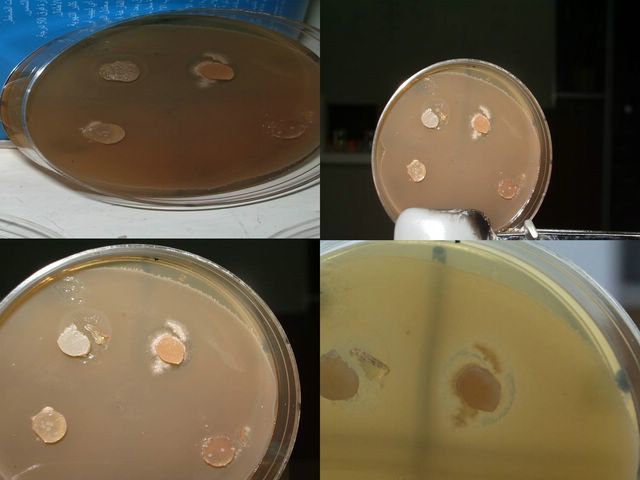
Aisla estreptomicina de un cultivo de Streptomyces. Albert Schatz

-
Se le considera como el inventor del microscopio compuesto (con dos lentes), conto con la ayuda de su padre, en el año 1595.
-
demostró que los insectos no nacen por generación espontánea, por lo que se le considera el fundador de la helmintología (el estudio de los gusanos) . Realizó estudios sobre el veneno de las víboras.
-
Introdujo mejoras en la fabricación de microscopios y fue el precursor de la biología experimental, la biología celular y la microbiología. Heredó la labor de Jan Swammerdam.
-
Le apasionó el problema de la regeneración espontánea de partes del cuerpo de anfibios y de reptiles aunque no pudo llegar a conclusiones satisfactorias.
-
Descubrimiento de la vacuna antivariólica tuvo trascendencia definitoria para combatir la viruela, enfermedad que se había convertido en una terrible epidemia en varios continentes.
-
Estudia una dolencia que atacaba al Bombyx mori gusano de seda, o "mal de sueño", conocido actualmente como muscardina. La larva se cubría de un polvo blanco y moría. los cultivos se devastecieron.
-
considerado padre de la Micología británica; llegando a describir muchísimas especies. Su herbario de cerca de 10 000 especies de champignones (con alrededor de 5 000 que describe).
-
Demostró que el cólera era causado por el consumo de aguas contaminadas con materias fecales, al comprobar que la enfermedad se agrupaban en las zonas donde el agua consumida estaba con heces.
-
Técnica conocida como pasteurización. A través de experimentos refutó definitivamente la teoría de la generación espontánea y desarrolló la teoría germinal de las enfermedades infecciosas.
-
Aisló varias moléculas ricas en fosfatos, a las cuales llamó nucleínas (actualmente ácidos nucleicos), a partir del núcleo de los glóbulos blancos, identificacion información hereditaria, el ADN.
-
Aislar el microorganismo causante de esta enfermedad y hacerlo crecer en un cultivo puro, utilizando este cultivo para inducir la enfermedad en animales de laboratorio, en su caso la cobaya. comparar.
-
Importancia del vector biológico a través de la teoría metaxénica de la transmisión de enfermedades por agentes biológicos, aplicándola a la fiebre amarilla transmitida por el mosquito Aedes aegypti.
-
aislar el microorganismo causante de esta enfermedad y hacerlo crecer en un cultivo puro, utilizando este cultivo para inducir la enfermedad en animales de laboratorio.
-
Tinción diferencial empleado en bacteriología para la visualización de bacterias, sobre todo en muestras clínicas.
-
teoría de la generación espontánea y desarrolló la teoría germinal de las enfermedades infecciosas.
-
Este bacilo fue incluido en el género de las bacterias, en la familia de la enterobacteriáceas.
-
placas de Petri, unos recipientes circulares inicialmente de vidrio (actualmente de plástico). utilizado en cultivo utilizados en bacteriología.
-
Responsable de la enfermedad del mosaico del tabaco es mucho más pequeño que una bacteria. Él los nombra virus. Descubre igualmente el principio de la fijación simbiótica del nitrógeno por leguminosas.
-
pionero de los conceptos de ciclos vitales, descubridor del proceso biológico de la nitrificación, la primera etapa del conocimiento de la quimioautotrofía.
-
Investigó una enfermedad que afectaba el tabaco, a la que se refirió como “contagium vivum fluidum”. agente infinitamente minúsculo capaz de impregnar los filtros de la porcelana.
-
codescubridor del agente infeccioso de la peste bubónica en Hong Kong en 1894, casi de manera simultánea con el biológo suizo Alexandre Yersin.
-
Estudió el desarrollo del ciclo vital de diferentes protozoos y coronó la labor de su vida con el descubrimiento, en colaboración con Erich Hoffman, de la espiroqueta Treponema pallidum.
-
fiebre amarilla se transmite por mosquitos, en vez de por contacto directo. Esta visión abrió campos completamente nuevos en epidemiología y biomedicina.
-
Aisló el microorganismo causante de la enfermedad (que él llamó rickettsia). Falleció por esa enfermedad. Dos diminutos cuerpos de aspecto lanceolado que, según él, eran los causantes de la enfermedad.
-
Bala mágica o salvarsán (arsfenamina), una preparación de arsénico orgánico empleada en el tratamiento de la sífilis y de la fiebre recurrente, y del neosalvarsán (neoarsfenamina).
-
Fue parte del descubrimiento del rol de los virus en la transmisión de ciertos tipos de cáncer. virus (retrovirus) que produce tumores (sarcomas) en pollos.
-
Descubrió los bacteriófagos, virus capaces de atacar y destruir diversas bacterias de forma específica.
-
Descubrimiento de los bacteriófagos (virus que sólo atacan y destruyen bacterias), además de ser el inventor de la terapia fágica.
-
Ha sido utilizado en muchos laboratorios de
Microbiología de todo el mundo y ha ido actualizándose a lo largo de los años hasta que apareció la
novena y última edición en 1994. -
Experimento conocido como "experimento de Griffith", descubrió lo que él llamó "principio de transformación", es decir lo que hoy en día se conoce como ADN.
-
Famoso por descubrir la enzima antimicrobiana llamada lisozima. También fue el primero en observar los efectos antibióticos de la penicilina obtenidos a partir del hongo Penicillium chrysogenum.
-
Su invención, que constituye una gran mejora en comparación con la teoría clásica del microscopio establecida por Abbe, se basó en que la luz reflejada por una superficie metálica experimenta.
-
Demostró que una bobina magnética podría actuar como una lente electrónica, y usó varias bobinas en una serie para construir el primer microscopio electrónico en 1933.
-
Sus investigaciones sobre el virus causante de la enfermedad del mosaico del tabaco le llevaron al descubrimiento y aislamiento de la nucleoproteína que controla su actividad infecciosa.
-
Una sulfamida (llamada en grupo sulfas) s una sustancia química sintética derivada de la sulfonamida, bacteriostática y de amplio espectro. Las sulfamidas se emplean como antibióticos, antiparasitar.
-
E ADN (ácido desoxiribonucleico) es el material del que los genes y los cromosomas están formados y de como estos definen la sexualidad del ser humano. Anteriormente se creía que eran la proteínas.
-
Reconocido por el descubrimiento de la estreptomicina, antibiótico usado para el tratamiento de la tuberculosis y otras enfermedades. Falleció víctima de un cáncer pancreático en Filadelfia en 2015.
-
Ls virus y las bacterias son microorganismos que pueden causar un sinnúmero de enfermedades; conocerlos es de gran utilidad para desarrollar acciones terapéuticas.
-
1796 - Edward Jenner desarrolla la primera vacuna contra la viruela humana.
-
Los plásmidos son moléculas de ADN extracromosómico circular o lineal que se replican y transmiten independientes del ADN cromosómico.
-
La estructura alanina del ARN de transferencia, ligado al ADN y a la síntesis proteica.El ARN de transferencia, ARN transferente o ARNt (tRNA en inglés) es un tipo de ácido ribonucleico encargado de transportar los aminoácidos a los ribosomas y ordenarlos a lo largo de la molécula de ARNm, a la cual se unen por medio de enlaces peptídicos para formar proteínas durante el proceso de síntesis proteica.
-
La viruela fue una enfermedad infecciosa grave, contagiosa, causada por el Variola virus, que en algunos casos podía provocar la muerte. No hubo nunca tratamiento especial para la viruela y las únicas formas de prevención eran la inoculación o la vacunación.
-
Haemophilus influenzae, anteriormente llamado bacilo de Pfeiffer o Bacillus influenzae, son cocobacilos Gram-negativo no móviles descritos en 1892 por Richard Pfeiffer durante una pandemia de gripe. Es generalmente aerobio pero puede crecer como anaerobio facultativo. H. influenzae fue considerado erróneamente como la causa de la gripe común hasta 1933, cuando la etiología viral de la gripe llegó a ser aparente
-
Thiomargarita namibiensis ("perla sulfurosa de Namibia") es una proteobacteria gram-negativa encontrada en los sedimentos oceánicos de la plataforma continental. Es la mayor bacteria conocida, con una longitud de hasta 750 μm (0,75 mm), lo que la hace visible a simple vista.
-
también conocida como influenza aviar, gripe del pollo o gripe de los pájaros, designa a una enfermedad infecciosa vírica y que afecta a las aves, aunque tiene suficiente potencial como para infectar a distintas especies de mamíferos, incluidos el ser humano, el cerdo y el gato doméstico.
-
En ocasiones los virus influenza porcinos pueden transmitirse al ser humano y producir enfermedad. El mecanismo de propagación suele ser gotitas respiratorias y aerosoles de los cerdos, que por contacto o proximidad física pasan a la boca, mucosas y vías aéreas del hombre. El principal factor de riesgo es la exposición laboral a cerdos
Looking for a timeline maker?
Create timelines for projects, roadmaps, history, lessons, legal cases, and stories with Timetoast. Timetoast is a timeline maker for work, school, research, and stories.